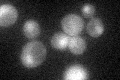
YJR046W
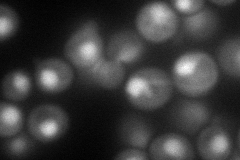
YJR046W
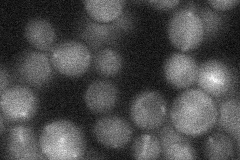
YJR046W
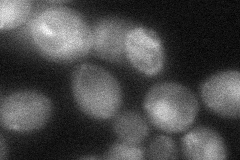
YJR046W
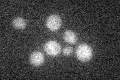
YJR046W

View description
DNA replication licensing factor, required for pre-replication complex assembly
Localization:
Intensity:
Fold change:
Significance:
-
C’ GFP library in SD
nucleus25.68 -
N' NOP1pr-GFP in SD

nucleus71.7014 -
N' TEF2pr-mCherry in SD
nucleus99.813 -
N' NATIVEpr-GFP in SD
cytosol22.351 -
N' TEF2pr-VC and Cyto-VN in SD
cytosol39.2334 -
C’ GFP library in SD+DTT

nucleus26.581.03No -
C’ GFP library in SD+H2O2

nucleus29.941.16No -
C’ GFP library in Starvation Media
nucleus19.080.74Yes -
C’ GFP library on the background of Pup2-DaMP

nucleus -
C’ GFP library on the background of CCT mutant

nucleus27.46461.06911No
